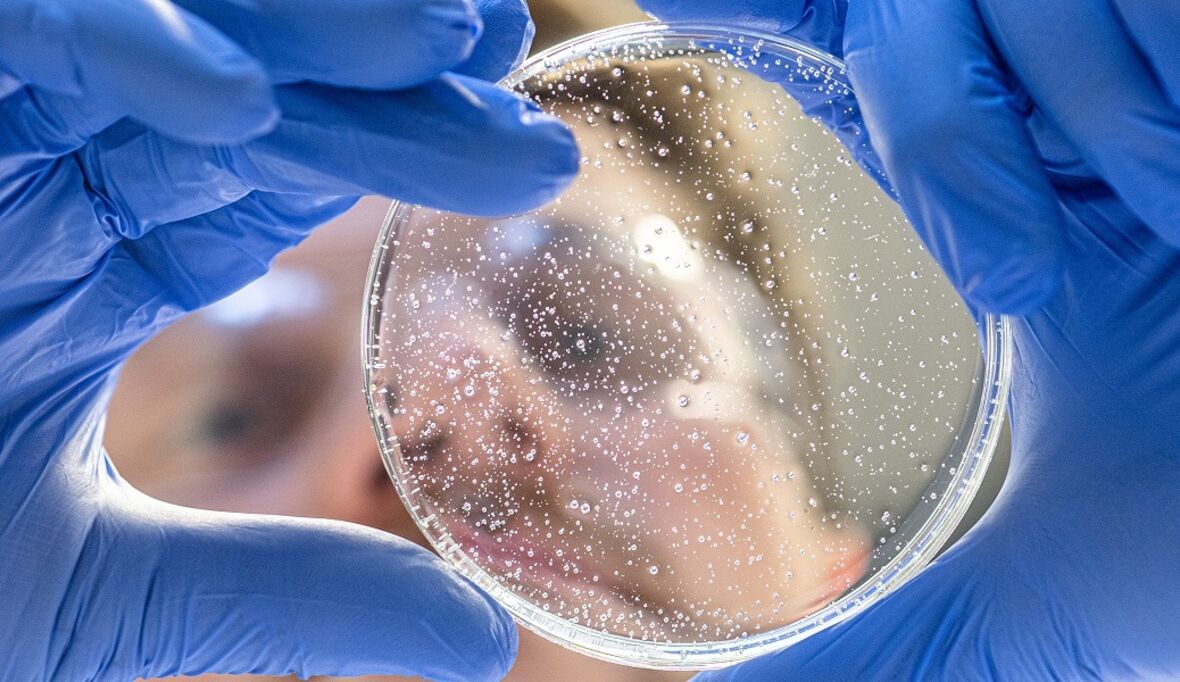

-

Sind Entrepreneurship-Aktivitäten von Unternehmen nur „Theater“?
Nicht nur in Fachkreisen gilt er als einer der einflussreichsten Unternehmer und Forscher weltweit, was Innovationen und Entrepreneurship angeht: Prof. Dr. Steve Blank von der renommierten ...
» -

Solartechnik nach Vorbild eines Schmetterlingsflügels
Photovoltaik- und Solarthermie-Anlagen wirken in ästhetischer Hinsicht an Gebäuden oft wie Fremdkörper. Forscherinnen und Forscher am Fraunhofer-Institut für Solare Energiesysteme ISE haben deshalb ...
» -
Verfahren könnte Edelmetalle bei der Silikonproduktion ersetzen
Silicone haben sich im privaten und im professionellen Bereich bewährt. Damit aus dem flüssigen Vorprodukt das elastische und haltbare Polymer wird, benötigt man jedoch in vielen Fällen teure ...
» -

Biologisch abbaubare Folien für die Landwirtschaft
In Silageballen wird durch Milchsäuregärung Futtermittel für Rinder und Kühe hergestellt. Diese sind allerdings nicht sonderlich naturnah. Der Grund: Bislang werden die dafür verwendeten Folien nach ...
» -

Gel aus Apfelschalen mit antioxidativen Eigenschaften
Die Freie Universität Bozen hat ihr erstes Patent angemeldet: Aus Rückständen der Apfelverarbeitung hat die Forschungsgruppe von Prof. Matteo Scampicchio ein Wachs gewonnen, das unter bestimmten ...
» -

Lithium aus dem Rhein?
Weltweit steigt der Bedarf an Lithium: Vor allem für die E-Mobilität ist der Rohstoff heiß begehrt. Um den tendenziell weiter steigenden Bedarf decken zu können, wird seit einigen Jahren auch die ...
» -

Lösungsmittel schaffen Kunststoff-Recycling
Forscher der University of Wisconsin am Standort Madison haben ein Verfahren entwickelt, mit dem sich Wertstoffe aus Plastikabfällen zurückgewinnen lassen. Das ist vor allem für die Hersteller von ...
» -

Innovationslabore für „grünen Wasserstoff“
Wasserstoff – erzeugt aus erneuerbaren Energien – als Baustein für die Energiewende und den Klimaschutz: Das Programm „Innovationslabore für Wasserstofftechnologien" des niedersächsischen ...
» -

Neue Produktionstechnologie für schwere Nutzfahrzeuge
Das EU-Klimaziel, den CO2-Ausstoß von neuen Pkw bis 2030 um 37,5 Prozent zu senken, soll bereits in fünf Jahren auch auf schwere Nutzfahrzeuge ausgedehnt werden. Forscher des Karlsruher Instituts für ...
» -

Wie wollen wir wirtschaften und produzieren?
Die Kläranlage wird zur Gemüsefarm, aus Abfällen zurückgewonnene biobasierte Stoffe verhindern in Lebensmittelverpackungen oxidativen Verderb oder liefern auf Funktionstextilien wasserabweisende ...
» -

Eingesperrte Algen liefern Wasserstoff
Forscher des Bristol Max Planck Centre for Minimal Biology und des Harbin Institute of Technology haben Algenzellen „umprogrammiert“, sodass sie statt Sauerstoff Wasserstoff produzieren, der als ...
» -

Maßnahmen gegen Corona-Übertragung durch Aerosole
In einer aktuellen Stellungnahme analysiert der Arbeitsausschuss Feinstäube (AAF) den Aerosol-Transmissionspfad der Corona-Pandemie genauer. Die Expertinnen und Experten gehen auf Gegenmaßnahmen ein ...
» -

Siebzehn Ziele für eine bessere Welt
Mit ihrem neuen Internetangebot humboldts17.de bietet die Humboldt-Universität zu Berlin eine neue Adresse zur Verbreitung wissenschaftlicher Erkenntnisse auf dem Gebiet der Nachhaltigkeit. Das ...
» -

Roboter sagt Bauern, wo sie bewässern müssen
Ein kleiner fahrbarer Roboter, der auf den Feldern patrouilliert, sagt Landwirten künftig, wo sie bewässern müssen und wie viel die Pflanzen benötigen. Die Innovation haben Forscher der University of ...
» -

Supercomputer made in Jülich setzt neue Maßstäbe
Das Forschungszentrum Jülich und seine Partner haben einen unvergleichlich flexiblen und energieeffizienten Supercomputer konstruiert – es ist der schnellste Rechner Europas. JUWELS kann die Grenzen ...
»
Unsere Verantwortung/Mitgliedschaften
© macondo publishing GmbH
Alle Rechte vorbehalten.


